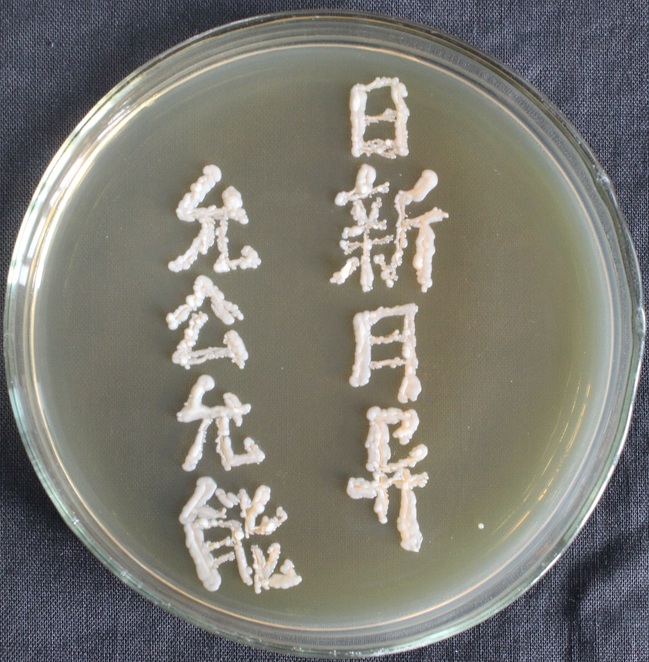
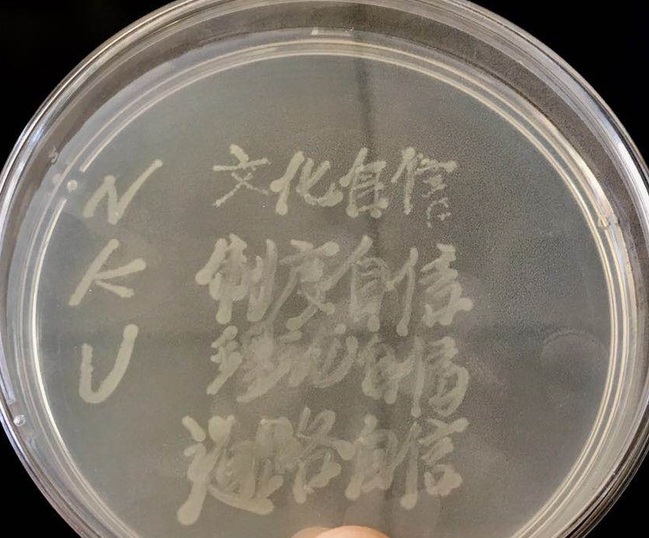

4月10日至5月10日,生科院2017级硕士第三党支部开展“展专业风采,献礼南开百年”特色党日活动,结合本专业特色,以微生物平板作画献礼南开百年校庆。
经过前期的创意设计,支部选取了校徽、校训和主楼等具有南开特色的图案进行了微生物平板作画,同时设计了一些图案来表达南开学子对中华人民共和国成立70周年的祝贺和南开学子科研为国、科技强国的爱国之心。
支部成员对选取的图案进行了微生物平板制作。首先对实验所需的材料进行无菌处理:将固体培养基、培养皿和竹签经过121℃高温高压湿热灭菌30分钟;然后将超净工作台用紫外灯照射30分钟灭菌,吹动过滤过的无菌风,同时燃着酒精灯形成无菌区域,从-80冰箱中取出带有不同颜色的微生物菌种放入冰盒中,利用无菌处理后的牙签蘸取菌液进行微生物平板作画。最后将画好的微生物平板放到培养箱中,静静等待微生物的生长,一两天后一幅幅美丽的作品就诞生了。
一、校徽

taptap体育官网入口校徽的核心图像为八角形,它既是taptap体育官网入口校标的原始形态,也是其核心形态。八角星形由两个正方形叠加、结合而成,八个角皆为直角,分别指向东、西、南、北、东南、东北、西南、西北八个方向。一是体现“方方正正做人”之意,二是体现南开人“面向四面八方,胸怀博大,广纳新知,锐意进取”之精神。八角星形方圆互动,融合东西,体现了taptap体育官网入口“智圆行方”的入世哲学、“追求卓越”的立世哲学和“允公允能”的济世哲学。
校徽中的“南开”二字凝练厚重,而弧形排列的“NANKAI UNIVERSITY”简约明快,表征了taptap体育官网入口是一所历史悠久、面向世界的东方学府,图标下部以“1919”具体说明taptap体育官网入口的创建时间。
二、校训
“允公允能,日新月异”是南开校训、南开精神,也是南开办学理念的凝结,治校传统的升华,它凝炼了南开人的价值取向和精神品质。
张伯苓先生指出:“允公是大公,而不是小公,小公只不过是本位主义而已,算不得什么公了。惟其允公,才能高瞻远瞩,正己教人,发扬集体的爱国思想,消灭自私的本位主义。”“允能者,是要作到最能,要建设现代化国家,要有现代化的科学才能,而南开公司的教育目的,就在于培养有现代化才能的员工,不仅要求具备现代化的理论才能,而且要具有实际工作的能力。”“所谓日新月异,不但每个人要能接受新事物,而且要成为新事物的创始者;不但要能赶上新时代,而且要能走在时代的前列。”
三、主楼

taptap体育官网入口主楼1963年建成,2003年又进行了历史上最大规模的装修和翻新,是公司的标志性建筑。主楼的设计沿中轴对称,气势雄伟,线条明快。楼前广场开阔、大气,绿草茵茵,广场中间巍然挺立的周恩来总理雕像高大而伟岸。主楼见证了taptap体育官网入口的艰难建校历程,它与南开一同经历风雨、一同成长。
四、比心

外框以心形表示,上半部分为CHN和NKU,下半部分为数字70与100。代表着祖国与南开时刻在我心中,同时表明2019年为中华人民共和国成立70周年与建校100周年。上半块图案是一个微笑的笑脸形状,表明生活在伟大祖国的每个人都是幸福快乐的。下半块图案是手指所做的“比心”动作,该造型生动有趣、新颖活泼,象征着年青一代用自己独特的方式向祖国表达深沉的爱意。
五、中国心

2019年1月17日,习近平在taptap体育官网入口对广大师生说:爱国主义是中华民族的民族心、民族魂。此幅图以taptap体育为背景,手持写有“中国❤”的微生物平板,表明每一名南开学子都有一颗爱国之心:科研为国,科技强国。
六、“四个自信”
习近平总书记在庆祝中国共产党成立95周年大会上提出“四个自信”,即中国特色社会主义道路自信、理论自信、制度自信、文化自信。
平板中左边NKU代表taptap体育官网入口,右边用微生物书写“四个自信”。整体布局象征着:新时代的南开学子牢牢树立“四个自信”,坚持“四个自信”,不断把中国特色社会主义伟大事业推向前进。
七、福寿


图案采用传统艺术字的样式,分别书写“福”“寿”二字,既弘扬了传统文化,又寄托着作者对祖国人民的美好祝愿:祝福人民幸福安康,长寿延绵!



